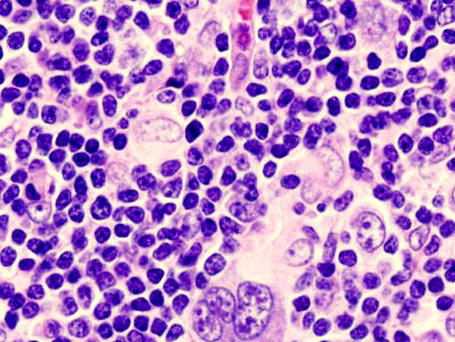

Лечение лимфомы по стандартам современной медицины
Лимфома — серьезное заболевание лимфатической системы. При своевременном и правильном подходе лечение этой болезни дает хорошие результаты. Поэтому не стоит медлить с обращением за профессиональной медицинской помощью.
Содержание:
- Лимфатическая система: небольшое досье
- Несколько слов о лимфоме
- Лимфома – основное о заболевании
- Стоимость лечения лимфомы в Израиле
- Почему развивается лимфома?
- Виды лимфом
- Стадии лимфомы
- Клинические проявления лимфом
- Как образуются метастазы при лимфоме
- Методы диагностики лимфомы в израильской клинике Ассута
- Лечение лимфомы в Ассуте
- Прогнозы при лимфоме
Лимфатическая система: небольшое досье
Лимфатическая система представляет собой некую паутину каналов (капилляров, сосудов), которые пронизывают весь организм и по которым движется лимфа (прозрачная жидкость, состоящая из большого количества белка). По ходу сосудов располагаются лимфатические узлы. Лимфатический сосуд «впадает» в лимфоузел. Здесь происходит фильтрация лимфы и ее обогащение лимфоцитами. После этого лимфа попадает в сосуд, который выходит из узла. В конечном итоге каждый лимфососуд соединяется с крупным лимфопротоком, а он уже впадает в вену.

Несколько слов о лимфоме
Лимфомами называется группа заболеваний онкологического характера, при которых поражается лимфоидная ткань. Специалисты выделяют большое множество разновидностей лимфом, которые различаются по иммуногистохимическим критериям и требуют различного подхода к терапии.
Специалисты Израиля имеют большой опыт лечения лимфом, и используют такие передовые методики как трансплантация стволовых клеток. Израильская онкогематология по праву считается одной из самых эффективных на планете.
Лимфома – основное о заболевании
Как это ни парадоксально, но лимфатическая ткань организма, призванная защищать его, в том числе и от рака, также подвержена злокачественным заболеваниям – лимфомам. Лимфатическая система представлена скоплениями лимфатических узлов по всему организму, вблизи всех органов, во всех полостях и участках тела. В них вырабатываются основные иммунные клетки – Т-лимфоциты и В-лимфоциты. При лимфоме процесс вызревания этих клеток нарушается, и они не только не выполняют своих защитных функций, но и становятся смертельно опасными для организма.
Лимфомы относятся к группе рака крови и занимают 5-е место среди всех онкологических заболеваний, частота развития лимфом растёт во всём мире:
- в США насчиты
вается около 90 тысяч больных лимфомой; - в России число больных лимфомами превышает 100 тысяч;
- наибольшая заболеваемость регистрируется в районах, близких к нефтедобывающим и нефтеперерабатывающим предприятиям;
- лимфомы часто развиваются на фоне снижения иммунитета – у больных СПИДом и ВИЧ-инфицированных, подвергшихся облучению, перенесших тяжёлые вирусные инфекции;
- высок риск развития лимфом у подвергающихся хроническим интоксикациям (алкоголь, наркотики, токсические факторы производства);
- факторами риска развития лимфомы являются сельскохозяйственные химикаты – пестициды и др.;
- лимфомы нередко развиваются при аутоиммунных заболеваниях у пациентов, принимающих иммуносупрессоры – средства для подавления иммунитета;
- лимфома является не локальной опухолью, а общим заболеванием организма, которое без лечения приводит к неминуемой гибели пациента.
Таковы не весьма радостные факты о лимфоме. И всё же, лечение лимфомы сегодня достаточно эффективное. Статистика ВОЗ говорит о том, среднее значение его эффективности в мире превышает 70%, а если углубиться в анализ, то лечение лимфомы за рубежом в развитых странах превышает 85% эффективности, и в частности, лечение в Израиле, где применяются самые новые и эффективные средства. Большая часть пациентов, приезжающих в Израиль, успешно проходят лечение лимфомы в Ассуте – крупнейшей современной частной клинике, соответствующей самым высоким мировым стандартам.
Почему развивается лимфома?
Точные причины лимфомы пока не названы, но медики уже определили перечень факторов, способных вызвать развитие болезни:
- сбои в работе иммунной системы,
- вирусные инфекции, долгое время воздействующие на организм,
- определенные лекарственные препараты, принимаемые на регулярной основе,
- реабилитационный период после пересадки органов (в это время врачи вынуждены искусственно подавлять работу иммунитета),
- СПИД, возникший на фоне вируса иммунодефицита,
- продолжительное влияние химических веществ на организм.
Не последнее место отводится и такому фактору, как возраст. Часто диагноз «лимфома» ставится пациентам в возрасте за 50 лет.
Виды лимфом
Все злокачественные заболевания лимфатической ткани лимфомы разделяют на 2 большие группы:
- лимфома Ходжкина (лимфогрануломатоз) – составляет 20% от общего числа лимфом;
- неходжкинские лимфомы, включающие до 30 видов.
Название первой группы произошло от имени английского онкогематолога Томаса Ходжкин, посвятившего этому заболеванию много научных работ. Этот вид лимфомы характеризуется более изолированным поражением лимфатических узлов, менее агрессивным и медленным развитием заболевания, и считается сегодня практически полностью излечимым.Все остальные лимфомы, отличающиеся от лимфогрануломатоза более агрессивным характером, объединены в группу неходжкинских лимфом (НХЛ). Они характеризуются системным поражением лимфоузлов и всех органов, быстрым клиническим развитием, тяжёлым состоянием пациентов.
Неходжкинские лимфомы разделяют на Т-клеточные и В-клеточные, в зависимости от того, какой вид лимфоцитов заболевает. Каждый из них, в свою очередь, включает различные подвиды лимфом:
- фолликулярная;
- плазмоклеточная;
- ангиоиммунобластная;
- крупноклеточная;
- грибовидная;
- лимфома Беркитта и другие виды.
Стадии лимфомы
- 1 стадия — локализация новообразования в одном лимфатическом узле или другой строго определенной
области. - 2 стадия — болезнь начинает прогрессировать и поражает несколько лимфатических узлов, расположенных с одной стороны по отношению к диафрагме.
- 3 стадия — патологические процесс становится более масштабным и уже охватывает лимфатические узлы с двух сторон диафрагмы.
- 4 стадия — образование множественных опухолей, лимфома поражает не только лимфатическую систему, но ЦНС, костный мозг.
Получить бесплатную консультацию
Клинические проявления лимфом
Основными клиническими симптомами лимфом являются:
- увеличение лимф
атических узлов (на шее, в паху, в подмышечных областях); повышение температуры тела – от субфебрильных до высоких цифр; - резкое снижение иммунитета, присоединение инфекций, гнойных заболеваний;
- геморрагический синдром – появление на коже кровоподтёков, кровоточивость дёсен, носовые кровотечения;
- потеря веса, снижение аппетита;
- анемия – бледная окраска кожи, головная боль, головокружение;
- резкая общая слабость, астения, нарушение сна.
Симптоматика НХЛ отличается острым и «бурным» течением, с поражением не только всех лимфоузлов, но и внутренних органов: появляются очаги в печени, селезёнке, почках, кишечнике, средостении, мозге и даже в глазном яблоке, функция всех этих органов нарушается, состояние пациентов, как правило, тяжёлое.
Как образуются метастазы при лимфоме
Лимфотической системе отведена важная роль — защищать организм, поддерживать работу иммунитета. Если развивается такое заболевание, как лимфома, то патологические лимфоциты легко разносятся по всему организму вместе с лимфой. По пути раковые клетки оседают и образуются метастазы.
Первыми от метастазов страдают шейные и надключичные лимфатические узлы — в 60-75% случаев. В 50% случаев поражаются узлы средостения. Редко, но все же, метастазы образуются и в лимфоузлах, которые находятся вдоль позвоночника.
В 25-30% поражается селезенка. Затем метастазы проникают в костную систему, ЦНС, печень.
Методы диагностики лимфомы в израильской клинике Ассута
Клиника Ассута – лечебное учреждение высокого класса и мирового уровня, оказывающее высоко профессиональную помощь пациентам с заболеваниями крови, в частности, с различными видами лимфом. Характерен оперативный и профессиональный подход к обследованию пациентов, которым в кратчайший срок после прибытия проводятся все необходимые диагностические процедуры: 
- развёрнутый анализ крови, в том числе с определением лимфомных клеток;
- иммунологическое и генетическое исследование;
- биопсия лимфатических узлов с гистологическим исследованием;
- биопсия костного мозга;
- спинальная пункция с исследованием спинальной жидкости
- ультразвуковое исследование лимфатической системы;
- полное томографическое исследование (КТГ, МРТ, ПЭТ, сцинтиграфия);
- инструментальные методы исследования (лапароскопия, торакоскопия);
- исследование центральной нервной системы, органа зрения.
Во время проведения диагностики лимфомы её дифференцируют со сходными по клиническому течению заболеваниями – токсоплазмозом, туберкулёзом, мононуклеозом, СПИДом, которые также сопровождаются увеличением лимфатических узлов, повышением температуры тела.
Лечение лимфомы в Ассуте

После тщательного обследования и оценки потенциала больного ему подбирают индивидуальную схему терапии, которая позволит наиболее эффективно бороться с болезнью. Основное лечение лимфомы за границей включает в себя химиотерапию, радиотерапию, иммунотерапию, трансплантацию костного мозга или стволовых клеток. В некоторых случаях требуется хирургическое удаление объемных образований в области лимфатических узлов.
При выборе метода и составления протокола лечения лимфомы в Израиле и, в частности, в клинике Ассута, руководствуются главным принципом – персонализацией пациента. То есть программа лечения содержит набор средств, оптимальных для данного больного, с особенностями его заболевания и состояния организма в целом.
Химиотерапия
Главным элементом программы лечения является химиотерапия, которая сочетает в себе несколько современных препаратов с различным механизмом воздействия. Арсенал препаратов довольно широк, и он систематически пополняется (флударабин, ритуксимаб, хлорбутин и др.).
Химиотерапия успешно сочетается с иммунными препаратами, среди которых лучше всего себя зарекомендовали моноклональные антитела. Они применяются в готовом виде, или же создаются в специальных иммунологических лабораториях для каждого пациента, на основе материала, полученного их поражённых лимфоузлов. Это так называемая целевая клеточная терапия направленного действия, которая совершенствуется и в перспективе имеет большое будущее в лечении лимфом.
Химиотерапия включает в себя проведения нескольких циклов лечения, которые можно проходить амбулаторно. Схема химиотерапии составляется совместно онкогематологом и химиотерапевтом, исходя из разновидности лимфомы и степени ее распространения в организме. Наиболее интенсивные программы применяются при лечении неходжкинских лимфом.
Экстракорпоральная гемосорбция
Параллельно с химиотерапией назначается экстракорпоральная гемосорбция – очистка крови от патологических лимфомных клеток вне организма пациента. Проводятся переливания препаратов крови – эритроцитарной и тромбоцитарной массы для устранения анемии и нормализации свёртывания. Забор крови осуществляется посредством периферической вены, после чего ее помещают в емкость, содержащую сорбент. В процессе очищения вредные вещества и патологические клетки оседают. Очищенную кровь вновь вводят больному.
Лучевая терапия (радиотерапия)
Лучевая терапия часто назначается в комбинации с химиотерапией, и применяется для местного лечения особенно агрессивных форм болезни. Ее проводят с целью уменьшения объема злокачественного образования, или уже в послеоперационном периоде для уничтожения оставшихся раковых клеток. Иммунотерапия
Иммунотерапия – новое направление в онкогематологии, подразумевает назначение биопрепаратов, стимулирующих собственные силы организма для борьбы с лимфомой. Она эффективна даже при запущенных случаях. Диагноз лимфома – не означает приговор для израильских специалистов. В зависимости от характера развития заболевания они подбирают наиболее подходящие способы проведения иммунотерапии:
- назначение терапевтических вакцин против рака,
- адаптивный перенос Т-лимфоцитов,
- использование моноклональных антител,
- применение иммуномодуляторов (препараты, нормализующие иммунные функции).
Трансплантация костного мозга
Хороший эффект в тяжёлых случаях (особенно при рецидивах) даёт трансплантация костного мозга, которая в Израиле имеет лучшие результаты приживаемости и эффективности. Трансплантация может быть:
- аутологической — донор не является близким родственником пациента,
- аллогенной — пересаживается собственный костный мозг больного,
- сингенной — донором становится близкий родственник.
Пересадка костного мозга увеличивает шансы на выживание до 80-90%. Во многих случаях пациенты полностью выздоравливают.

Результаты лечения лимфомы в Израиле очень высоки: лимфогрануломатоз излечивается полностью, а 5-летняя выживаемость при неходжкинских лимфомах превышает 85%.
Медицинский центр Ассута является крупнейшим израильским частным медицинским учреждением. Онкогематологическое отделение Ассута оснащено самым современным оборудованием, в нем работают лучшие специалисты Израиля в этой области, многие из которых имеют мировое имя.
Лечение лимфомы в Израиле начинается с тщательной диагностики, специалисты проверяют все имеющиеся у пациента исследования и назначают дополнительные. Помимо неинвазивных методов обследования (компьютерная томография, магнитно-резонансная томография, позитронно-эмиссионная томография), активно применяется биопсия лимфатических узлов с последующим гистологическим обследованием, стернальная пункция, спинномозговая пункция с изучением ликвора, лапароскопия и другие инвазивные процедуры.
Онкогематологи Израиля оценивают потенциальный рост опухоли и эффективность терапии по международному прогностическому индексу. Чтобы его рассчитывать используются 5 основных факторов (возраст больного, стадия лимфомы, наличие вторичных очагов роста, общее состояние здоровья и лабораторные показатели).
Прогнозы при лимфоме
В случае с лимфомой выживаемость зависит от вида заболевания. Лимфомы Ходжкина (ЛХ) имеют более благоприятные прогнозы, чем неходжкинские лимфомы.
В 95% и более достигается длительная ремиссия при НХЛ. Если ремиссия длится пять лет, то прогнозируется выживаемость в 80% случаев.
Комбинированная химиотерапия позволяет добиться полной ремиссии в 50% случаев при ЛХ 2-3 стадии. Достижение стойкой ремиссии увеличивает прогноз выживаемости до 90%.
Хорошие прогнозы дают доктора на ранней стадии НХЛ. Если появляются метастазы, то выживаемость составляет не более 30%.
Неагрессивная лимфома 1 стадии подлежит излечению в 100% случаев, если лечение проходит в клиниках с современным оборудованием, такой как Ассута.
При лимфоме 4 стадии прогнозы пятилетней выживаемости более 67%. Выживаемость в течение 15 лет прогнозируется в 56% случаев.
Стоимость лечения лимфомы в Израиле
Лечение лимфомы за границей стоит недешево. Израильские клиники предлагают эффективное лечение с применением новейших технологий по вполне доступным ценам, которые могут быть ниже на 20-50% от стоимости терапии в клиниках Европы или Америки. Заполните форму заявки, чтобы специалисты рассчитали вам предварительную цену на лечение. Окончательная стоимость терапии будет определена только в процессе обследования и лечения, и во многом зависит от реакции болезни на начатый процесс терапии. 
Лечение лимфомы за рубежом соизмеримо с лечением лейкемии по методам и материальным затратам, и размер их, разумеется, немалый. Однако общеизвестно, что самые доступные цены на лечение среди стран зарубежья практикует онкология Израиля, в том числе и при лечении лимфом. К тому же на лечение лимфомы в Израиле у детей практикуется система бесплатных консультаций и скидок на лечение. Разница в стоимости лечения лимфомы в Израиле между клиниками незначительная, и ориентировочно она будет выглядеть следующим образом:
|
Наименование процедуры |
Стоимость в $ США |
|
Консультация гематолога |
550 |
|
Полное лабораторное исследование, в том числе на лимфомные клетки, биохимию, специфические белки и т.д. |
1370 |
|
Биопсия лимфоузла под УЗИ-контролем со срочным гистохимическим исследованием |
от 3000 |
|
Биопсия костного мозга |
от 4000 |
|
Удаление лимфоузла (шейного, пахового, брюшного) |
6000 - 9000 |
|
Полный курс химиотерапии (в зависимости от протокола) |
2000 - 7500 |
|
Пересадка костного мозга (все этапы, включая медикаментозную подготовку химиотерапией и радиотерапией) |
70000 - 90000 |
Следует учесть, что цены на аналогичные процедуры в Западной Европе в среднем выше на 15-20%, а в США – на 40-60%.
Заполните форму контакта на сайте, и наши сотрудники рассчитают предварительную стоимость лечения в вашем случае.
Лимфома входит в перечень наиболее опасных для жизни заболеваний. При этом врачам Ассуты удается добиваться одних из лучших в мире результатов по ее излечению. Мы лечим не только тело, но и душу. С пациентами и их родственниками работают профессиональные психологи. Обращайтесь в нашу клинику, вместе мы обязательно победим любую болезнь!

WhatsApp Сообщение




